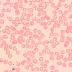

Mikroskop MAGUS Bio 250TL je dôveryhodný profesionálny biologický mikroskop navrhnutý pre pozorovanie tenkých rezov a stierov biologických vzoriek v prechádzajúcom svetle. Základnou technikou je svetlé pole, ale mikroskop je možné rozšíriť o tmavé pole, polarizačné zariadenie alebo fázový kontrast vďaka kompatibilnému príslušenstvu (nie je súčasťou balenia).
Trinokulárna hlava so samostatným vertikálnym tubusom pre digitálny fotoaparát (nie je súčasťou) je otočná o 360° a naklonená o 30°, čo zaisťuje pohodlie aj pri dlhodobom pozorovaní. Dioptrická korekcia na ľavom tubuse prispôsobí mikroskop individuálnym potrebám používateľa.
Optický systém je vybavený rovinnými achromatickými objektívmi s korekciou na nekonečno, ktoré poskytujú jasný, kontrastný obraz s minimálnym skreslením. Rozsah zväčšenia 40-1000x je možné pomocou volitelného príslušenstva ďalej rozšíriť až na 2500x.
Osvetlenie zabezpečuje 3 W LED dióda s nastaviteľným jasom a dlhou životnosťou až 50 000 hodín. Farebná teplota zostáva stabilná aj pri zmene jasu, čo umožňuje prirodzené zobrazenie vzoriek. Vďaka výškovo nastaviteľnému Abbeho kondenzoru s aperturnou a polnou clonou je možné nastaviť Köhlerovo osvetlenie. Kondenzor je vybavený slotom pre posuvníky tmavého poľa alebo fázového kontrastu, čo umožňuje rýchle prepínanie medzi rôznymi metódami pozorovania.
Ergonomický dvojvrstvový stolík bez polohovacieho stojanu zaisťuje dostatok priestoru nad vzorkou. Koaxiálny mechanizmus hrubého a jemného zaostrenia umožňuje plynulé a presné nastavenie ostrosti s možnosťou nastavenia tuhosti a aretácie hrubého zaostrenia.
Obsah balenia:
-
Základňa mikroskopu s napájaním a osvetlením
-
Trinokulárna hlava otočná o 360°
-
Rovinné achromatické objektívy s korekciou na nekonečno:
-
Širokouhlé okuláre 10x/22 mm s dlhým očným reliéfom (2 ks)
-
Očnice (2 ks)
-
Abbeho kondenzor N.A. 1,25 s výškovým nastavením, aperturnou a polnou clonou, slotom pre posuvníky
-
Filtre: modrý, zelený, žltý
-
Adaptér pre fotoaparát s držiakom C-mount
-
Lahvička s imerzním olejom
-
Sieťový napájací kábel
-
Protiprašný kryt
-
Používateľská príručka a záručný list

Převodem
Na fakturu
Dobírka
Převodem
Na fakturu
Dobírka